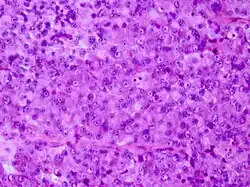

Crooke-Zelle

Als Crooke-Zellen werden hyalinisierte basophile Zellen der Adenohypophyse bezeichnet, die von dem englischen Endokrinologen Arthur Carleton Crooke (1905–1990) erstmals beschrieben wurden.[1] Charakteristisch ist auch die ringförmige Einlagerung von Zytokeratinen.[2][3]
Crooke-Zellen stellen sekundäre regressive Veränderungen ACTH-produzierender Zellen der Adenohypophyse bei Hyperkortisolismus dar und werden typischerweise beim Cushing-Syndrom, aber auch nach medikamentöser Kortisongabe im nichtneoplastischen adenohypophysealen Gewebe beobachtet.
Hiervon abzugrenzen ist das sogenannte Crooke-Zelladenom, eine seltene Variante des ACTH-Zelladenoms, dessen Tumorzellen die Morphologie von Crooke-Zellen aufweisen.[2]
Einzelnachweise
- ↑ Crooke: A change in the basophile cells of the pituitary gland common to conditions which exhibit the syndrome attributed to basophile adenoma. In: J Pathol, 1935, 41, S. 339–349.
- ↑ a b George et al.: Crooke’s cell adenoma of the pituitary: an aggressive variant of corticotroph adenoma. In: Am J Surg Pathol. 2003 Oct, 27(10), S. 1330–1336. PMID 14508394
- ↑ Eschbacher, Coons: Cytokeratin CK20 is a sensitive marker for Crooke’s cells and the early cytoskeletal changes associated with hypercortisolism within pituitary corticotrophs. In: Endocr Pathol., 2006, 17(4), S. 365–376. PMID 17525485